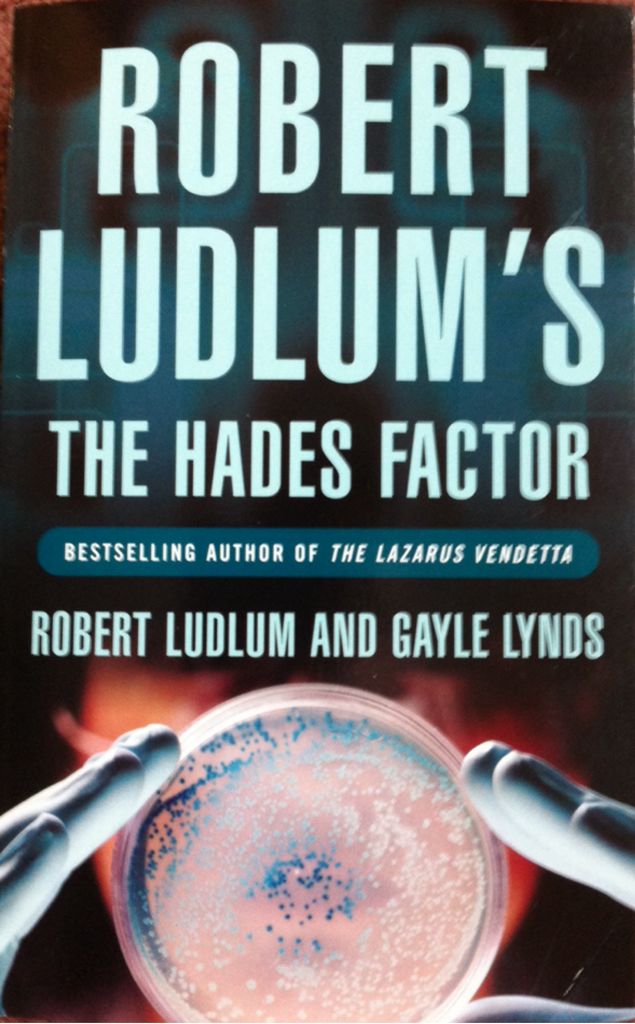
Crescent Dawn

Title:
Blindsight
Genre:
Fantasy
Romance
Science Fiction
Supernatural
Show More
Binding:
Hardcover
Type of Book:
Fiction
Number of Chapters:
16
Date Added:
2018-06-26 18:15:23
Synopsis:
Robin Cook is back — with a shocking story of medical conspiracy. Today, organ transplants are common miracles of science. But if the supply cannot meet the demand, how far will people go to find donors? Dr. Laurie Montgomery, a forensic pathologist, learns the terrifying answer when she investigates a series of fatal "overdose” of young professionals. Some crimes are beyond comprehension. But seeing is believing...
Author:
Robin Cook
Show More
Date Added:
2018-06-26 18:15:23